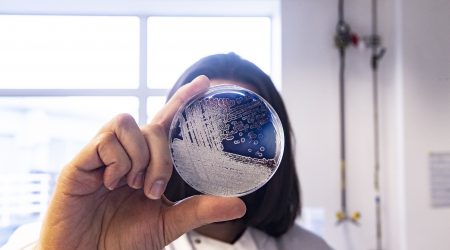

Learning Resources
Over the years we have created a variety of plant and microbial science resources designed for scientists of all ages.
Read about learning resourcesFind out more about our offering for schools and young people.

Over the years we have created a variety of plant and microbial science resources designed for scientists of all ages.
Read about learning resources
We are passionate about inspiring and enabling the next generation of STEMM professionals.
Read about work experience
There are many pathways to a career in STEM (Science Technology Engineering and Maths). Watch and listen to the diverse career stories of our staff and students, both past and present.
Read about career pathways
SAW brings science to life through stimulating creative activities combining Science, Art and Writing.
Read about the saw trust
The Teacher Scientist Network (TSN) was established in 1994 to link the education and science communities in Norfolk.
Read about teacher scientist network
Empowering Young People in Science, Technology, Engineering, Maths and Medicine.
Read about youth stemm awards (ysa)
The Education Programme is supported by the John Innes Foundation.
Read about our funding